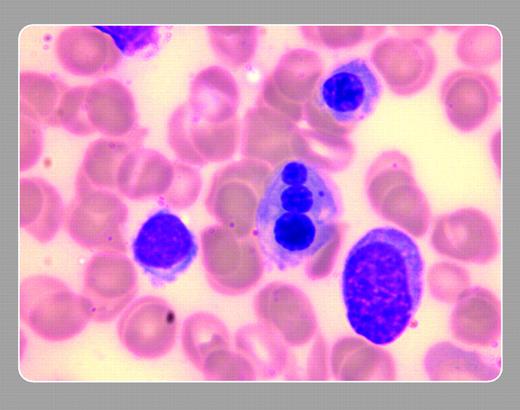
Jiri Pavlu and Nicki Panoskaltsis, Imperial College London

A 69-year-old man was found to have pancytopenia. His hemoglobin level was 118 g/L with a normal mean corpuscular volume, white cell count 3.4 × 109/L, neutrophil count 1.7 × 109/L and platelet count 83 × 109/L. Blood smear showed dysplastic neutrophils, and the bone marrow aspirate confirmed myelodysplastic syndrome with 8% blasts (RAEB-1). He had trilineage dysplastic changes with prominent micromegakaryocytes and dyserythropoiesis. The nuclei of one of these dysplastic, polychromatic normoblasts took on the form of a snowman and is shown in the figure. Cytogenetic analysis revealed complex karyotype with rearrangements of chromosomes 7, 12, and 20, resulting in a partial deletion of 20q.FIG1
Many Blood Work images are provided by the ASH IMAGE BANK, a reference and teaching tool that is continually updated with new atlas images and images of case studies. For more information or to contribute to the Image Bank, visit www.ashimagebank.org.

Jiri Pavlu and Nicki Panoskaltsis, Imperial College London
Jiri Pavlu and Nicki Panoskaltsis, Imperial College London
This feature is available to Subscribers Only
Sign In or Create an Account Close Modal